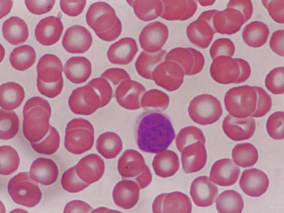
肺炎限制了idelalisib和entospletinib用于复发难治性CLL和NHL

-
男46岁,因间歇性无痛性肉眼血尿5个月入院
环球医学资讯
 2016年06月20日
2016年06月20日 点击量:608
点击量:608 1小时条评论
1小时条评论患者男性,深圳人,46岁。 主诉:间歇性无痛性肉眼血尿5个月。 现病史:患者5个月前无明显诱因出现间歇性无痛性肉眼血尿,褐红色,偶伴小血块,无腰痛、发热,无尿少、排尿中断,无尿频、尿急、尿痛,无夜尿增多、排尿困难等,于外院就诊,确诊膀胱癌,单发,位于...
-
癌症患者:硼替佐米的毒性谱和最优剂量
环球医学资讯
 2016年06月13日
2016年06月13日 点击量:433
点击量:433 1小时条评论
1小时条评论硼替佐米用于多发性骨髓瘤患者的治疗。2016年4月发表在《J Clin Oncol》的一项在美国开展的研究使用来自完成的硼替佐米剂量识别试验的数据,考察其毒性谱,优化其剂量,并检查旨在确定最佳剂量的当前设计的适当性。 目的:当前评估试验抗癌药物最大耐受剂量的剂量识...
-
局限性前列腺癌患者:血清维生素D与不良病理过程的…
环球医学资讯
 2016年06月12日
2016年06月12日 点击量:188
点击量:188 1小时条评论
1小时条评论根治性前列腺切除术是第一种用于治疗前列腺癌的方法,也是治愈局限性前列腺癌最有效的方法之一。2016年4月发表在《J Clin Oncol》的一项在美国开展的研究考察了行根治性前列腺切除术患者中,血清维生素D与不良病理过程的关系。 目的:血清维生素D水平降低与侵袭性前...
-
多发性骨髓瘤患者接受硼替佐米治疗有何获益?
环球医学资讯
 2016年06月12日
2016年06月12日 点击量:283
点击量:283 1小时条评论
1小时条评论硼替佐米用于多发性骨髓瘤患者的治疗。2016年4月,发表在《Cochrane Database Syst Rev》的一项由爱尔兰科学家进行的系统评价和Meta分析表明,与未接受硼替佐米的患者相比,接受硼替佐米治疗的多发性骨髓瘤患者能够从总生存期、无进展生存期和应答率上获益。 背景:...
-
癌症患者不同蒽环类药物剂量方案心脏毒性的发生率
环球医学资讯
 2016年06月12日
2016年06月12日 点击量:348
点击量:348 1小时条评论
1小时条评论使用蒽环类药物的化疗是目前最有效的抗癌疗法之一。2016年3月发表在《Cochrane Database Syst Rev》的一项由荷兰科学家进行的综述更新考察了正接受蒽环类药物化疗的癌症患者中,降低心脏毒性的不同剂量方案。 背景:本综述更新由儿童癌症和Cochrane妇科、神经肿瘤和...
-
晚期喉癌化疗:顺铂+5-氟尿嘧啶是否添加多西他赛?
环球医学资讯
 2016年06月12日
2016年06月12日 点击量:118
点击量:118 1小时条评论
1小时条评论原发性喉癌以鳞状细胞癌最为常见。2015年12月发表在《J Natl Cancer Inst》的一项在法国开展的研究表明,在使用诱导化疗的喉保留法中,TPF优于PF。 背景:GORTEC 2000ndash;01的目的是比较对于喉保留,使用顺铂(P)和5-氟尿嘧啶(F)plusmn;多西他赛(T)的诱导化...
-
多学科讨论:免疫调节药物维持治疗可改善多发性骨髓…
环球医学资讯
 2016年06月12日
2016年06月12日 点击量:402
点击量:402 1小时条评论
1小时条评论【导读】多发性骨髓瘤是一种血液系统的恶性肿瘤,发病年龄一般在40岁以上。2015年11月发表在《J Natl Cancer Inst》的一项系统评价和荟萃分析表明,基于沙利度胺或来那度胺的维持治疗改善多发性骨髓瘤的无进展生存期而非总生存期,并增加3~4级不良事件风险。临床药...
-
肺炎限制了idelalisib和entospletinib用于复发难治…
环球医学资讯
 2016年06月08日
2016年06月08日 点击量:567
点击量:567 1小时条评论
1小时条评论近年来,针对B细胞信号通路(BCR)上不同成分的靶向药物在B细胞肿瘤的临床试验中取得良好的治疗效果。2016年5月,发表于《Blood》一项研究评估了idelalisib联合entospletinib治疗复发/难治性慢性淋巴细胞白血病(CLL)或非霍奇金淋巴瘤(NHL)患者的安全性及有效性。...
-
多学科讨论:发现CAR-T细胞治疗用于B细胞恶性肿瘤新…
环球医学资讯
 2016年06月08日
2016年06月08日 点击量:347
点击量:347 1小时条评论
1小时条评论【导读】刚过去的5月发生的魏则西事件,让普通大众对肿瘤的细胞免疫治疗有了一定的了解。在肿瘤界,细胞免疫治疗也是研究热点。细胞免疫治疗是否真的有效?影响细胞免疫治疗疗效的因素是什么?2016年5月,发表在《Blood》的一项研究发现了CAR-T细胞治疗用于CD19+B细...
-
多学科讨论:二甲双胍可化学预防结直肠癌?
环球医学资讯
 2016年06月07日
2016年06月07日 点击量:371
点击量:371 1小时条评论
1小时条评论【导读】既往研究发现,2型糖尿病患者患癌风险高,二甲双胍能降低糖尿病患者患癌风险,其中包括降低结直肠癌风险。但2016年3月发生在《Lancet Oncol》的一项研究却显示,二甲双胍预防结直肠癌或与糖尿病无关,二甲双胍对息肉切除术后的非糖尿病患者的结直肠腺瘤或息...

会员登录
会员登录

